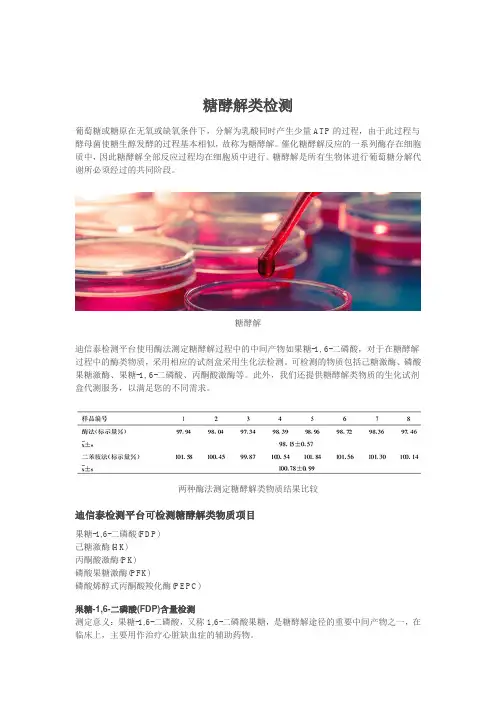

磷酸烯醇式丙酮酸羧化酶(PEPC)活性检测试剂盒说明书 微量法
- 格式:pdf
- 大小:168.32 KB
- 文档页数:3

2. 实验试剂:50mM ATP溶液,50mM磷酸肌酸溶液,0.2mM NaHCO3溶液,160U/ml 磷酸肌酸激酶溶液,160U/ml磷酸甘油酸激酶溶液,160U/ml磷酸甘油醛脱氢酶溶液(U为酶活力单位),25mM RuBP溶液,5mM NADH,Rubisco提取介质(40mM Tris-HCl缓冲液,pH7.6,内含10mM MgCl2溶液,0.25mM EDTA,5mM谷胱甘肽),反应介质(0.1M Tris-HCl缓冲液,pH7.8,内含12mM MgCl2溶液,0.4mM EDTA)。
3实验步骤3.1 酶粗提液的准备取新鲜洗干净的条斑紫菜的丝状体和条斑紫菜的叶状体各1克,加入预冷的提取介质1ml,冰浴研磨10min,将样品在40C,10,000×g离心10min,弃沉淀;上清夜即是酶粗提液,置于00C备用(王维光,1985;张志良等,2003)。
3.3.2 Rubisco酶活力的测定按下表配制反应体系:试剂加入量ml5mM NADH 0.250mM ATP 0.2酶提取液0.150mM磷酸肌酸0.20.2mM NaHCO30.2反应介质1.4160U/ml磷酸肌酸激酶0.1160U/ml磷酸甘油酸激酶0.1160U/ml磷酸甘油醛脱氢酶0.1双蒸水0.3将配制好的反应体系混匀,倒入比色杯内,以蒸馏水为空白,在紫外分光光度计计上测量340nm处反应体系的OD值,作为零点值。
将0.1mlRuBp加入比色杯内,立即计时,每隔20s测一次OD值,共测3min。
以零点到第1min 的OD值下降的绝对值计算酶活力。
由于酶提取液中可能存在3-磷酸甘油酸(PGA),会使酶活力的测定产生误差,因此除上述测定外还需做一个不加RuBp的对照。
对照的反应体系与上述酶的反应体系完全一样,所不同的仅仅是把酶提取液放在最后加,加入后马上测定此反应体系340nm处的OD值,并记录前1min内OD值的变化量。

3种石斛PEPC羧化酶活力比较任建武;王雁;彭镇华;张连成【摘要】石斛属植物具有兼性景天酸代谢植物特征,磷酸烯醇式丙酮酸羧化酶是该类植物碳代谢的关键酶.本研究选用3种石斛为材料,测定了其磷酸烯醇式丙酮酸羧化酶活性.结果表明,报春石斛晚间黑暗条件下酶活性较强,凌晨高达25μmolC02/ (m2·s),而在中午光照最充足时,酶的活性相对较弱;金钗石斛酶活性日变化特点与报春石斛相似,但是活性比较弱;鼓槌石斛的酶活性很弱,通常在8μmolC02/( m2 · s)以下,昼夜变化幅度很小,表现为黑暗状态下比光下更强.%The species within the genus of Dendrobium exhibited the characteristics of facultative Cras-sulacean acid metabolism plants. Aiming at clarifying carbon assimilation pathway of dendrobium, three Dendrobia were employed in this study, and measurement of PEPC activity was conducted by the means of ultraviolet spectrophotometer. The results indicated that PEPC activity of D. Primulinum from dark leaves was as strong as 25μmolC02/ ( m2 ? S) early morning, whilst it was relative ly weak at noon when sun light was bright, which to some certain concluded that D. Primulinum showed the characteristics of CAM plant. In terms of diurnal fluctuation of PEPC activity in D. Nobile was resembled to D. Primulinum. The PEPC activity in D. Chrysotoxum was very weak as below 8 |xmol CO2/ (m2 ? S) , and the magnitude of diurnal fluctuation was small as comparing to other two objects; anyway, its activity from dark leaves was stronger than one from illuminated leaves, the data from the trials means that D. Chrysotoxum is inclined to acting via C3 pathway.【期刊名称】《云南农业大学学报》【年(卷),期】2011(026)006【总页数】6页(P815-820)【关键词】石斛;景天酸代谢;磷酸烯醇式丙酮酸羧化酶【作者】任建武;王雁;彭镇华;张连成【作者单位】北京林业大学生物科学与技术学院,北京100083;中国林业科学研究院林业研究所,北京100091;中国林业科学研究院林业研究所,北京100091;中国林业科学研究院林业研究所,北京100091;天津市滨海新区塘沽林业站,天津300450【正文语种】中文【中图分类】S682.31.01石斛属 (Dendrobium)为兰科 (Orchidaceae)的大属之一,包括1 400种[1],分布于亚洲赤道两侧,南至大洋洲。

货号:MS2204 规格:100管/96样丙酮酸(pyruvic acid PA)含量测定试剂盒说明书微量法正式测定前务必取2-3个预期差异较大的样本做预测定测定意义:丙酮酸通过乙酰CoA连接葡萄糖、脂肪酸和氨基酸三大代谢,起着重要的枢纽作用。
测定原理:丙酮酸与2,4-二硝基苯肼作用,生成丙酮酸-2,4-二硝基苯腙,在碱性溶液中呈显色。
自备实验用品及仪器:可见分光光度计/酶标仪、台式离心机、可调式移液器、微量石英比色皿/96孔板、研钵、冰、蒸馏水。
试剂的组成和配制:提取液:液体100mL×1瓶,4℃保存;试剂一:液体2.5mL×1瓶,4℃避光保存;试剂二:液体12.5mL×1瓶,4℃保存。
丙酮酸提取:1、细菌或培养细胞:先收集细菌或细胞到离心管内,离心后弃上清;按照细菌或细胞数量(104个):提取液体积(mL)为500~1000:1的比例(建议500万细菌或细胞加入1mL提取液),超声波破碎(冰浴,功率20%或200W,超声3s,间隔10s,重复30次),静置30min, 8000g,25℃离心10min,取上清待测。
2、组织:按照组织质量(g):提取液体积(mL)为1:5~10的比例(建议称取约0.1g组织,加入1mL提取液),进行冰浴匀浆,静置30min,8000g,25℃离心10min,取上清待测。
3、血清(浆)样品:按照血清(浆)体积(mL):提取液体积(mL)为1:5~10的比例(建议取0.1mL血清(浆)加入1mL提取液),进行冰浴匀浆,静置30min, 8000g,25℃离心10min,取上清待测。
测定步骤:1、分光光度计或酶标仪预热30min以上,调节波长至520nm,蒸馏水调零。
2、在微量石英比色皿或96孔板中加入75μL样本和25μL试剂一,混匀,静置2min,加入125μL试剂二,混匀,于520nm波长处测定管吸光值A。
丙酮酸含量计算:a.用微量石英比色皿测定的计算公式如下1、标准条件下测定回归方程为y = 0.0466x + 0.0675; x为丙酮酸含量(µg/mL),y为吸光值。

二氧化碳测定试剂盒(PEPC酶法)产品技术要求zhongshengbeikong 二氧化碳测定试剂盒(PEPC酶法)适用范围:本产品用于体外定量测定人血清中二氧化碳的浓度。
1.1包装规格液体单剂型试剂(R):20mL×4,校准品:3mL×1;试剂(R):20mL×6,校准品:3mL×1。
1.2主要组成成分试剂(R)液体:磷酸烯醇式丙酮酸(PEP) 12.5mmol/L磷酸烯醇式丙酮酸羧化酶(PEPC) 400U/L) 8.0mmol/L氯化镁(MgCl2苹果酸脱氢酶(MDH) 4100U/L还原辅因子 0.6mmol/L校准品液体:水溶液基质(1个浓度)碳酸氢钠目标浓度25.0 mmol/L(每批定值,详见值单) 2.1 外观试剂盒中各组件的外观应满足:2.1.1试剂(R)应为浅黄绿色透明溶液,无杂质、无絮状物,外包装完整无破损。
2.1.2校准品应为无色透明溶液,无杂质、无絮状物,外包装完整无破损。
2.2 净含量液体试剂净含量应不少于标示值。
2.3 试剂空白吸光度在波长400nm~420nm(光径1cm)处,试剂空白吸光度(A)应≥0.600;试剂空白吸光度变化率(△A/min)应≤0.015。
2.4准确度测定GBW06101,测定结果的相对偏差应不超过±10%。
2.5分析灵敏度对应于浓度为 25mmol/L的二氧化碳所引起的吸光度变化率(△A/min)的绝对值应在0.010~0.080的范围内。
2.6重复性重复测试高、中、低浓度样本,变异系数(CV)应≤10%。
2.7批间差测试同一样本,批间差(R)应≤10%。
2.8线性范围在[3,60]mmol/L范围内,线性相关系数(r)应≥0.990;在(25,60]mmol/L范围内,线性相对偏差应不超过±10%;在[3 ,25]mmol/L范围内,线性绝对偏差应不超过±2.5mmol/L2.9试剂稳定性2.9.1效期稳定性原包装的试剂盒在2℃~8℃避光贮存,有效期为12个月。

二氧化碳(CO2)测定试剂盒(PEPC酶法)说明书【产品名称】二氧化碳(CO2)测定试剂盒(PEPC酶法)【包装规格】a)单一试剂:1×15mLb)单一试剂:2×40mLc)单一试剂:5×60mLd)单一试剂:2×100mL【预期用途】用于体外定量测定人血清中二氧化碳的含量。
血液中CO2含量对人体内酸碱平衡的调节起着重要的作用。
增高:代谢性碱中毒,如幽门梗阻、柯兴综合征等。
呼吸性酸中毒,如呼吸中枢抑制、呼吸机麻痹等。
降低:代谢性酸中毒,如严重腹泻、肾功能衰竭等。
慢性呼吸碱中毒[1]。
临床上测定二氧化碳代谢性与呼吸性酸、碱中毒的辅助诊断,通常与pH值同时进行。
【检验原理】样本中的碳酸氢根在磷酸烯醇式丙酮酸羧化酶(PEPC)催化下,与磷酸烯醇式丙酮酸(PEP)反应,生成草酰乙酸和磷酸;草酰乙酸在苹果酸脱氢酶(MDH)催化下,生成苹果酸,同时NADH被氧化成NAD+,NADH被氧化的程度与碳酸氢根的含量成正相关。
【主要组成成分】试剂主要组分三羟甲基氨基甲烷缓冲液250mmol/L磷酸烯醇式丙酮酸(PEP)10g/L磷酸烯醇式丙酮酸羧化酶(PEPC)10KU/L苹果酸脱氢酶(MDH)8KU/L还原型辅酶I(NADH) 2.2g/L表面活性剂及稳定剂适量注:不同批号试剂盒中各组分未经试验不可互换。
【储存条件及有效期】1.试剂原包装在2~8℃储存,有效期为12个月,生产日期、有效期见标签。
2.开口后的试剂在仪器仓中(2~8℃)可稳定30天。
【适用仪器】艾威德AS-420/AS-660/AS-1200;日立HITACHI7020型/7060型/7180型/7600型/LABOSPECT008AS型;贝克曼AU400/AU480/AU640/AU680/ AU2700/AU5400/AU5800/AU5811/AU5821;佳能TBA-FX8/TBA-120FR/ TBA-2000FR;罗氏cobas8000c702/cobas8000c701/cobas8000c502;西门子SIEMENS ADVIA1800/ADVIA2400;雅培ABBOTT ARCHITECT c8000/ARCHITECT c16000/ARCHITECT ci8200;西森美康SYSMEX BM6010/C;科华KHB卓越310/卓越330/卓越400/卓越450/ZY-1200/ ZY-1280;迪瑞CS-240/CS-T300/CS-300B/CS-380/CS-400A/CS-400B/ CS-600A/CS-600B/CS-800A/CS-800B/CS-1200/CS-1200ISE/CS-1300B/CS-14 00;迈瑞MINDRAY BS-220/BS-330/BS-350E/BS-380/BS-390/BS-400/BS-430/ BS-600/BS-800/BS-2000M;颐兰贝ES-200/ES-380/ES-480;赛诺迈德SUNMATIK-9050型;雷杜Chemray420;英诺华D280;特康TC6010L;锦瑞GS400;普康6066。

2021年 2月 Journal of Science of Teachers′ College and University Feb. 2021文章编号:1007-9831(2021)02-0054-07植物磷酸烯醇式丙酮酸羧化酶的研究进展于济1,2,沙伟1,2,张梅娟1,2,马天意1,2(齐齐哈尔大学 1. 生命科学与农林学院,2. 抗性基因工程与寒地生物多样性保护黑龙江重点实验室,黑龙江 齐齐哈尔 161006)摘要:磷酸烯醇式丙酮酸羧化酶(Phosphoenolpyruvate carboxylase,PEPC,EC 4.1.1.31)是广泛存在的一种细胞质酶,催化磷酸烯醇式丙酮酸和HCO3-生成草酰乙酸.PEPC作用的产物在植物的生长发育过程和植物应对环境胁迫反应中起到调控的作用,因而被广泛关注.介绍了植物PEPC的种类、结构特征、不同物种中PEPC基因的克隆与分离、在植物逆境反应中的应用、植物PEPC 的活性调节,为深入研究PEPC基因提供理论依据.关键词:磷酸烯醇式丙酮酸羧化酶;植物;植物逆境胁迫中图分类号:Q945 文献标识码:A doi:10.3969/j.issn.1007-9831.2021.02.011Research progress of plant phosphoenolpyruvate carboxylaseYU Ji1,2,SHA Wei1,2,ZHANG Meijuan1,2,MA Tianyi1,2(1. School of Life Sciences,Agriculture and Forestry,2. Heilongjiang Provincial Key Laboratory of Resistance Gene Engineering andProtection of Biodiversity in Cold Areas,Qiqihar University,Qiqihar 161006,China)Abstract:Plant phosphoenolpyruvate carboxylase(PEPC,EC 4.1.1.31)is a ubiquitous cytoplasmic enzyme that catalyzes the production of Oxaloacetate by phosphoenolpyruvate and HCO3-.The products of PEPC play important roles in the growth and development of plants and the responses of plants to environmental stresses,so that the PEPC is widely concerned.Introduced the types,structural characteristics,the cloning and isolation of PEPC genes in different species,the applications in plant stress responses,and the researches of plant PEPC activity regulation,which provides a theoretical basis for further studiesof PEPC genes.Key words:phosphoenolpyruvate carboxylase;plant;plant stress responses磷酸烯醇式丙酮酸羧化酶(Phosphoenolpyruvate carboxylase,PEPC,EC 4.1.1.31)是一种胞质酶,在HCO3-存在的情况下,可以催化磷酸烯醇式丙酮酸(Phosphoenolpyruvate,PEP)的β-羧化反应,以Mg2+为辅因子生成草酰乙酸(Oxobutanedioic acid,OAA)和无机磷酸[1]70,此反应为不可逆反应.PEPC存在于所有植物中,如绿藻、蓝细菌、大多数古细菌、非光合细菌中,但在动物和真菌中不存在[2]15. PEPC以其在C4和景天酸代谢(Crassulacean acid metabolism,CAM)光合作用中的作用而闻名,在此过程中,其初步固定了大气中的CO2[3]274.然而,PEPC在C3植物的非光合和光合组织中也发挥着广泛的作用,它可以通过补充C4-二羧酸进行能量和生物合成代谢,主要起抗衰老作用[4-5].在C3植物叶片和非光合收稿日期:2020-11-15基金项目:齐齐哈尔大学大学生创新创业训练计划项目(202010232817);黑龙江省省属高等学校基本科研业务费青年创新人才项目(135309364);黑龙江省省属高等学校基本科研业务费科研项目植物性食品加工技术特色学科专项(YSTSXK201876);黑龙江省人力资源和社会保障厅2018年省级留学回国人员择优资助项目作者简介:于济(1997-),女,吉林松原人,在读硕士研究生,从事植物逆境分子遗传学研究.E-mail:*****************通信作者:马天意(1989-),男,黑龙江齐齐哈尔人,讲师,博士,从事植物逆境分子遗传学研究.E-mail:********************组织中,PEPC的主要作用是在三羧酸循环中补充中间体,以及后面的氮同化和各种生物合成途径[3]274.此外,PEPC还参与了广泛的生理和发育过程,包括种子萌发和发育、果实成熟、豆科植物根瘤固氮等,在气孔保卫细胞中提供苹果酸以及增强了对渗透压和生物胁迫的耐受性[2,6-9].正是因为PEPC在植物中发挥着非常重要的作用,因此被人们广泛关注.为了更好地了解植物体中的磷酸烯醇式丙酮酸羧化酶基因的作用机制,本文概括分析了植物磷酸烯醇式丙酮酸羧化酶基因的分类、功能、分离与克隆、活性调节以及在植物抵抗逆境过程中的作用等方面的研究结果,介绍了磷酸烯醇式丙酮酸羧化酶基因在基因工程方面的应用,也为进一步研究磷酸烯醇式丙酮酸羧化酶基因提供了理论基础.1 PEPC的基本结构1984年,首先从大肠杆菌(Escherichia coli)克隆的PEPC基因推导了PEPC的一级结构[10].目前,已经分别在植物和细菌中发现了许多PEPC序列,包括同一生物体中的同工型,并且大约500个部分序列已经记录在GenBank中,主要用于系统发育重建[11-12].系统进化树显示,这些PEPC是从相同的祖先进化而来的[3,13].PEPC多肽的大小随生物体的种类而异:细菌、维管束植物、蓝细菌、原生动物(如疟疾病原体)的氨基酸残基数量大约为870(100 kDa),970(110 kDa),1010(116 kDa)或1150(134 kDa)[1]71.尽管已知古细菌的亚基大小非常小(约60 kDa),并且没有常见的变构调节子,但尚无来自古细菌的PEPC 序列数据[14-15].此外,还寻找了藻类PEPC的序列数据,因为硒的纯化亚型之一是由3种不同的亚基组成的[16],这种新的PEPC类型也在发育中的蓖麻(Ricinus communis)种子中被发现[17].在拟南芥(Arabidopsis thaliana)基因组序列中确定了另一种新的进入高等植物PEPC的第4种亚型[18],在分子大小上与蓝细菌的PEPC相似,并且缺少N端磷酸化位点,这是植物PEPC的标志.在植物和微生物界的多样性和广泛分布使得PEPC成为系统发育分析中最有趣的目标之一.对PEPC序列的比对表明,大约100个残基始终是保守的(相同的),另外100个残基是保守的具有相似的氨基酸残基的,对于成对的陆地植物酶,其识别率超过71%,因为C末端是高度保守的,所以长度的任何差异似乎是由于在N末端或内部区域(大约10个基因位点)处添加或插入了额外的序列而引起的.所制备的重组PEPCs的数量和特征仍是有限的,所涉及的物种目前不超过15个[1]71,因此有必要做进一步的工作.2 植物PEPC的分类及生理生化功能PEPC基因已大致分为2个亚家族,分为植物型PEPC(PTPC)和细菌型PEPC(BTPC)[19]11.PTPC表现出高度的遗传保守性,并在其100~110 kDa蛋白质中包含高度保守的N末端丝氨酸磷酸化基序和关键的C末端四肽QNTG[1,20].相比较而言,116~118 kDa的BTPC蛋白质显示低序列相似性并包含1个类似原核的C端(R/K)NTG四肽基序[17,21].PTPC典型地存在于同型四聚体-1类PEPCs中,而BTPCs作为调节和催化亚基存在于超常的异质配合物中(2类PEPCs)[2]26.PTPC又可以分为C4,C3和根特异亚型[21-22],它们在植物细胞中发挥着不同的功能.植物中PEPC的C3,C4类型至少在3个关键方面不同[23]:(1)C4型的PEPC通过吸收C4和CAM物种中的大气CO2参与了CO2浓缩机制的第1步,C3型PEPC存在于所有植物中,它参与多种生理功能,如三羧酸循环中中间体的补给,OAA的合成以及随后的苹果酸及其衍生物的合成[2]15.(2)C4型PEPC存在于叶肉细胞中,其表达方式对实现C4光合循环具有重要意义[24],而C3型的PEPC分布在C3和/或C4植物的不同组织中,起到管家的作用[22]865.(3)C4型PEPC的底物(PEP)饱和常数(Km)高于C3型,并且显示更多对苹果酸的耐受性,但是在一些植物物种中(如南美白菊科(Chenopodiaceae)植物和异子蓬(Suaedaaralocaspica))尚未将不同的PEPC区分为C3或C4类型,仅命名为ppc-1,ppc-2[25],它们的功能需要进一步验证.3 植物PEPC基因的分离与克隆1953年,植物的磷酸烯醇式丙酮酸羧化酶从菠菜(Spinacia oleracea)叶中首次被分离出来.目前,PEPC基因已在多种植物中被鉴定和研究,拟南芥和水稻(Oryzasativa)中分别报道4,6个PEPC家族成员[18,26],在大豆(Glycine max)中共鉴定到10个PEPC基因(GmPEPC1~10),其中GmPEPC6,GmPEPC8,GmPEPC9被铝毒、寒害、盐害等非生物胁迫诱导表达[27].花生(Arachis hypogaea)基因组报道5个PEPC 基因(AhPEPC1~5)[28],涂嘉琦[29]等从蔓花生(Arachis duranensis)基因组中鉴定到9个PEPC基因.马海洋[30]等从菠萝(Ananas comosus)基因组中鉴定出3个PEPC基因.邵姁[31]等从蓝莓(Vaccinium corymbosum)果实中克隆到磷酸烯醇式丙酮酸羧化酶编码基因VcPEPC,该基因开放阅读框全长为2 907 bp,可编码968个氨基酸,分子量为110.59 kD.赵晋锋[32]等从谷子(Setariaitalica)基因组中鉴定出1个SiPEPC基因,进一步研究表明,SiPEPC基因在拔节期和抽穗期正常光照强度下参与了对干旱胁迫的响应,推测SiPEPC基因参与了谷子对非生物逆境的应答,可能在干旱和其它逆境胁迫信号途径中起关键作用.4 植物PEPC基因在植物逆境反应中的作用非生物胁迫(如盐度、干旱、高温)通常会对植物的光合作用产生负面影响[33]901.PEPC已被建议用于支持主要的生理代谢途径(即三羧酸循环中中间体的补给等),以帮助植物和微生物避免和/或耐受极端的环境胁迫[7,34].在水分胁迫下,PEPC介导PEP的羧基化为OAA,随后合成苹果酸和渗透活性化合物(糖、氨基酸、糖醇)以帮助植物耐受水分胁迫[34-35].铝的积累、磷和铁的缺乏导致PEPC的上调,从而增加了包括苹果酸和柠檬酸在内的有机酸合成[36-38].有机酸向土壤中的排泄不仅可以增加磷和铁的可溶性形态并为植物所利用,还可以与Al3+形成稳定的配合物,从而降低毒性[39].生物应激(如病毒感染)也可以诱导PEPC的高活性,推测PEPC可以在防御作用中增强植物抗毒素、氨基酸、蛋白质的合成[40-41].也有研究表明,番茄(Lycopersicon esculentum)PEPC基因在盐、冷、植物激素胁迫下均有不同表达[19]15.可以推测PEPC 对植物的生长发育和抗逆性起一定作用.5 PEPC基因的应用目前,已经在多种植物物种中使用了不同PEPC基因作为改善作物的手段.如在水稻中,C4-PEPC使转基因水稻具有耐旱性,但叶绿体定位的PEPC对铵同化至关重要[42].玉米(Zea mays)C4型PEPC基因在小麦(Triticum aestivum)受体内实现了正确的转录和准确的剪接,也证明了玉米C4型PEPC基因在小麦中表现了一定的光合生理效应[43].以转甘蔗(Saccharum officinarum)PEPC基因的籼稻植株和非转基因的植株为研究材料,发现在光合效率和产量相关性状方面,转甘蔗PEPC基因植株都有较大提高,可以实现增产目的[44].张桂芳[45]等首次将含有稗草(Echinochloacrusgalli)根型的PEPC基因对水稻进行遗传转化,研究结果表明,转基因水稻的PEPC活性最高,为对照的5.85倍,植株叶片的净光合速率(Pn)较对照相比提高了20.0%.尹吴[46]等发现,与对照相比,转玉米PEPC基因的杨树表现出较强的光利用能力,其羧化能力和酶活性与对照相比最高可分别增加62.3%,38.6%.最近有研究表明,许多PEPC基因在增强对各种非生物和生物胁迫的耐受性中起调节作用.在干旱和盐胁迫下,PEPC的过度表达增强了耐受性[8]1513,但抑制导致转基因植物对渗透胁迫的敏感性增加[47].同样,拟南芥AtPPC4也可能在干旱胁迫中发挥作用[33]906.然而,表达PEPC的马铃薯(Solanum tuberosum)转基因植株表现出整体有机氮含量的增加,但淀粉和可溶性糖含量有所损失[48].6 植物组织中PEPC的活性调节PEPC通常由4个相同的亚基组成,相对分子质量约为95~110 kDa.大多数PEPC是变构酶,具有多种变构效应物,具体取决于生物的种类[1]70.此外,维管植物PEPCs通过位于N末端附近的保守丝氨酸处的可逆磷酸化来调节[49].目前解析了来自大肠杆菌和玉米的PEPC三维结构[50-51],这种结构信息以及通过定点诱变获得的信息为长期以来一直深入研究的催化和变构调节的分子机理提供了启示. 大多数PEPC都受变构调节,维管植物的效应仅限于一组效应类型,双子叶植物的PEPCs被葡萄糖6-磷酸(G6P)激活,并被L-苹果酸或天冬氨酸抑制,而单子叶植物的PEPC被甘氨酸或丙氨酸进一步激活[52]154.相反,大肠杆菌PEPC受更复杂的方式调节,被乙酰辅酶A、果糖1,6-双磷酸、长链脂肪酸、鸟苷3′-二磷酸5′-二磷酸激活,并被天冬氨酸或L-苹果酸抑制[53].此外,细菌PEPC中不存在的调节性磷酸化是植物PEPC中固有的[1]73.调节性磷酸化后,PEP的半饱和浓度略有降低,而抑制剂的半饱和浓度在包含底物和Mg2+生理浓度的反应混合物中增加了约2.7倍[52]155.Tovar-Mendez[52,54-55]等采用目前可用的最明确的玉米C4-PEPC制剂进行了全面的动力学分析,从生理条件下的动力学测量清楚地表明了变构效应子和磷酸化的重要性.S形PEP饱和度曲线归因于附加的PEP与G6P位点的结合[1]73,这些研究成功地应用了变构调控的协调过渡模型来描述玉米C4-PEPC的动力学行为,并且通过快速动力学分析观察到伴随变构过渡的构象变化[56].PEPC的活性在多个层次上受到调节.变构控制由调节PEPC活性(尤其是在细胞质pH值下)的正(葡萄糖6-P,甘氨酸)、负(L-苹果酸,天冬氨酸)效应子施加[3]280.此外,C4-PEPC通过光依赖性磷酸烯醇丙酮酸羧化酶激酶(Phosphoenolpyruvate carboxylase kinase,PEPCK)进行调节性磷酸化[57].PEPC的磷酸化形式与去磷酸化形式的动力学性质不同,如更高的最大反应速率对PEP的亲和力更高,对变构效应子的敏感性有所改变,从而减轻了苹果酸对其抑制作用,并增强了其对葡萄糖-6-P和甘氨酸的活化作用[58-59].高粱(Sorghum bicolor)中所有PTPC(SbPPC1-5)均含有带有保守丝氨酸的N末端磷酸化结构域,BTPC (SbPPC6)中不存在此域,PEPCK基因家族包括3个基因(SbPPCK1~3)[60],在叶肉细胞中,SbPPCK1的表达是由光触发的,其转录本在叶肉中比束鞘细胞更为丰富,由于这些原因,它被认为是光合异构体,其中SbPPCK2和SbPPCK3的功能未知[61].另一种可能调控PEPC活性的翻译后修饰(Post-translational modification,PTM)是保守的赖氨酸残基的单泛素化作用,使该酶对苹果酸和天冬氨酸更加敏感[62-64].据报道,该PTM(仅针对C3型PEPCs)存在于蓖麻种子[62]、Hakea prostata种子[63]、高粱种子[64-65]、拟南芥叶片[65-66]中.此外,在不同的植物组织(叶片、保卫细胞、根、果实)[67-70]以及大麦(Hordeum vulgare)、小麦、高粱种子[71-74]中还报道了2条免疫反应性PTPC条带,表明上部条带是下部条带的单泛素化形式.PEPC改变了该酶的动力学特性,从而干扰了其与PEP结合的能力,并增强了其对大多数代谢物效应子的敏感性[62]29656.7 展望植物磷酸烯醇式丙酮酸羧化酶作为C4型光合途径的关键酶,对其结构特点、代谢途径已有较为深入的研究[75].现在PEPC基因已经在越来越多的植物中被发现,并对其功能进行研究探索.在C4和CAM植物中,PEPC的作用以及其基因表征信息比较详细,但在C3植物中PEPC表达的细节报道很少,仍需进一步探索.转PEPC基因植物也在不同方面表达出PEPC基因对植物的调控功能,PEPC作为植物中广泛存在的酶,其在植物应对环境胁迫过程中的作用逐渐被发现,尤其是CAM植物中的大多数物种具有较高抗逆性,而这之中PEPC的相关功能机制还有待进一步挖掘,因此有必要进一步对PEPC基因在植物抗逆性研究中的作用进行详细探索.参考文献:[1] Izui K,Matsumura H,Furumoto T,et al.Phosphoenolpyruvate carboxylase:a new era of structural biology[J].Annual reviewof plant biology,2004,55:69-84[2] O′Leary B,Park J,Plaxton W C.The remarkable diversity of plant PEPC(phosphoenolpyruvate carboxylase):recent insightsinto the physiological functions and post-translational controls of non-photosynthetic PEPCs[J].The biochemical journal,2011(1):15-34[3] Chollet R,Vidal J,O'Leary M H.PHOSPHOENOLPYRUVATE CARBOXYLASE:A Ubiquitous,Highly Regulated Enzyme inPlants[J].Annual review of plant physiology and plant molecular biology,1996,47:273-298[4] Driever S M,Kromdijk J.Will C3crops enhanced with the C4CO2-concentrating mechanism live up to their full potential(yield)?[J].Journal of experimental botany,2013,64(13):3925-3935[5] Masumoto C,Miyazawa S,Ohkawa H.Phosphoenolpyruvate carboxylase intrinsically located in the chloroplast of rice plays acrucial role in ammonium assimilation[J].Proceedings of the National Academy of Sciences of the United States of America,2010,107(11):5226-5231[6] Cousins A B,Baroli I,Badger M R,et al.The role of phosphoenolpyruvate carboxylase during C4 photosynthetic isotope exchangeand stomatal conductance[J].Plant physiology,2007,145(3):1006-1017[7] O′Leary B,Fedosejevs E T,Hill A T,et al.Tissue-specific expression and post-translational modifications of plant-andbacterial-type phosphoenolpyruvate carboxylase isozymes of the castor oil plant,Ricinus communis L[J].Journal of experimental botany,2011,62(15):5485-5495[8] Qin N,Xu W,Hu L,et al.Erratum to:Drought tolerance and proteomics studies of transgenic wheat containing the maize C4phosphoenolpyruvate carboxylase(PEPC)gene[J].Protoplasma,2016,253(6):1513[9] 蔡小宁,陈茜,杨平,等.磷酸烯醇式丙酮酸羧化酶的生物信息学分析[J].安徽农业科学,2008(3):914-916[10] Fujita N,Miwa T,Ishijima S,et al.The primary structure of phosphoenolpyruvate carboxylase of Escherichia coli.Nucleotidesequence of the PPC gene and deduced amino acid sequence[J].Journal of biochemistry,1984(4):909-916[11] BesnardG,Offmann B,Robert C,et al.Assessment of the C4 phosphoenolpyruvate carboxylase gene diversity in grasses(Poaceae)[J].Theor Appl Genet,2002,105(2-3):404-412[12] Gehrig H,Heute V,Kluge M.New partial sequences of phosphoenolpyruvate carboxylase as molecular phylogeneticmarkers[J].Molecular phylogenetics and evolution,2001,20(2):262-274[13] Svensson P,Blasing O,Westhoff P,et al.Evolution of C4 phosphoenolpyruvate carboxylase[J].Archives of Biochemistry andBiophysics,2003,414(2):180-188[14] Sako Y,Takai K,Nishizaka T,et al.Biochemical relationship of phosphoenolpyruvate carboxylases(PEPCs)from thermophilicarchaea[J].Fems Microbiology Letters,1997,153(1):159-165[15] Sako Y,Takai K,Uchida A,et al.Purification and characterization of phosphoenolpyruvate carboxylase from the hyperthermophilicarchaeon Methanothermussociabilis[J].FEBS Letters,1996,392(2):148-152[16] Rivoal J,Trzos S,Gage D A,et al.Two unrelated phosphoenolpyruvate carboxylase polypeptides physically interact in the highmolecular mass isoforms of this enzyme in the unicellular green alga Selenastrumminutum[J].The journal of biological chemistry,2001,276(16):12588-12597[17] Blonde J D,Plaxton W C.Structural and kinetic properties of high and low molecular mass phosphoenolpyruvate carboxylaseisoforms from the endosperm of developing castor oilseeds[J].The journal of biological chemistry,2003,278(14):11867-11873 [18] Sánchez R,Cejudo F J.Identification and expression analysis of a gene encoding a bacterial-type phosphoenolpyruvate carboxylasefrom Arabidopsis and rice[J].Plant physiology,2003(2):949-957[19] Waseem M,Ahmad F.The phosphoenolpyruvate carboxylase gene family identification and expression analysis under abiotic andphytohormone stresses in Solanum lycopersicum L[J].Gene,2019,690:11-20[20] Xu W,Ahmed S,Moriyama H,et al.The importance of the strictly conserved,C-terminal glycine residue in phosphoenolpyruvatecarboxylase for overall catalysis:mutagenesis and truncation of GLY-961 in the sorghum C4leaf isoform[J].The journal of biological chemistry,2006,281(25):17238-17245[21] Gennidakis S,Rao S,Greenham K,et al.Bacterial-and plant-type phosphoenolpyruvate carboxylase polypeptides interact in thehetero-oligomeric Class-2 PEPC complex of developing castor oil seeds[J].The plant journal:for cell and molecular biology,2007(5):839-849[22] Dong L Y,Masuda T,Kawamura T,et al.Cloning,expression,and characterization of a root-form phosphoenolpyruvate carboxylasefrom Zea mays:comparison with the C4-form enzyme[J].Plant & cell physiology,1998,39(8):865-873[23] Gehrig H,Faist K,Kluge M.Identification of phosphoenolpyruvate carboxylase isoforms in leaf,stem and roots of the obligate CAMplant Vanilla planifolia Salib.(Orchidaceae):a physiological and molecular approach[J].Plant molecular biology,1998,38(6):1215-1223[24] Stockhaus J,Schlue U,Koczor M,et al.The promoter of the gene encoding the C4 Form of phosphoenolpyruvate carboxylase directsmesophyll-specific expression in transgenic C4Flaveriaspp[J].The plant cell,1997,9(4):479-489[25] Rosnow J J,Edwards G E,Roalson E H.Positive selection of Kranz and non-Kranz C4 phosphoenolpyruvate carboxylase aminoacids in Suaedoideae(Chenopodiaceae)[J].Journal of experimental botany,2014,65(13):3595-3607[26] Muramatsu M,Suzuki R,Yamazaki T,et al.Comparison of plant-type phosphoenolpyruvate carboxylases from rice:identificationof two plant-specific regulatory regions of the allosteric enzyme[J].Plant & cell physiology,2015,56(3):468-480[27] Wang N,Zhong X,Cong Y,et al.Genome-wide Analysis of Phosphoenolpyruvate Carboxylase Gene Family and Their Responseto Abiotic Stresses in Soybean[J].Sci Rep,2016(6):38448[28] Shanlin Y U,Pan L,Yang Q,et al.Identification and expression analysis of the phosphoenolpyruvate carboxylase gene family inpeanut(Arachis hypogaea L.)[J].Agricultural Sciences in China,2010,9(4):477-487[29] 涂嘉琦,甘璐,冯兰兰,等.蔓花生PEPC基因家族的生物信息学分析[J].热带亚热带植物学报,2018,26(2):107-115[30] 马海洋,赵秋芳,陈曙,等.菠萝PEPC基因家族的生物信息学分析[J].热带作物学报,2020,41(1):97-103[31] 邵姁,王月,应炎标,等.蓝莓磷酸烯醇式丙酮酸羧化酶基因cDNA克隆及表达分析[J].基因组学与应用生物学,2016,35(1):166-171[32] 赵晋锋,王高鸿,杜艳伟,等.谷子磷酸烯醇式丙酮酸羧化酶基因(PEPC)对逆境胁迫的响应[J].华北农学报,2019,34(4):67-74[33] Sánchez R,Flores A,Cejudo F J.Arabidopsis phosphoenolpyruvate carboxylase genes encode immunologically unrelatedpolypeptides and are differentially expressed in response to drought and salt stress[J].Planta,2006,223(5):901-909 [34] Doubnerová V,Rylavá H.What can enzymes of C4 photosynthesis do for C3 plants under stress?[J].Plant science:an internationaljournal of experimental plant biology,2011,180(4):575-583[35] Seki M,Umezawa T,Urano K,et al.Regulatory metabolic networks in drought stress responses[J].Current opinion in plantbiology,2007,10(3):296-302[36] Ma J F,Furukawa J.Recent progress in the research of external Al detoxification in higher plants:a minireview[J].Journal ofinorganic biochemistry,2003,97(1):46-51[37] Gregory A L,Hurley B A,Tran H T,et al.In vivo regulatory phosphorylation of the phosphoenolpyruvate carboxylase AtPPC1 inphosphate-starved Arabidopsis thaliana[J].The biochemical journal,2009(1):57-65[38] López-Millán A F,Morales F,Andaluz S,et al.Responses of sugar beet roots to iron deficiency.Changes in carbon assimilationand oxygen use[J].Plant physiology,2000(2):885-898[39] Rangel A F,Rao I M,Braun H P,et al.Aluminum resistance in common bean(Phaseolus vulgaris)involves induction andmaintenance of citrate exudation from root apices[J].Physiologia plantarum,2010(2):176-190[40] Ryslava H,Muller K,Semoradova S,et al.Photosynthesis and activity of phosphoenolpyruvate carboxylase in Nicotiana tabacum L.Leaves infected by potato virus A and potato virus Y[J].Photosynthetica,2003,41(3):357-363[41] Müller K,Doubnerová V,Synková H,et al.Regulation of phosphoenolpyruvate carboxylase in PVY(NTN)-infected tobaccoplants[J].Biological chemistry,2009,390(3):245-251[42] Liu X,Li X,Zhang C,et al.Phosphoenolpyruvate carboxylase regulation in C4-PEPC-expressing transgenic rice during earlyresponses to drought stress[J].Physiologia plantarum,2017(2):178-200[43] 陈绪清,张晓东,梁荣奇,等.玉米C4型PEPC基因的分子克隆及其在小麦的转基因研究[J].科学通报,2004(19):1976-1982[44] 马宏敏.转PEPC基因籼稻恢复系“N175”产量相关性状分析[J].福建农业科技,2014(8):1-2[45] 张桂芳,丁在松,赵明.稗草(Echinochloacrusgalli)根型PPC基因对水稻的遗传转化及其对光合速率的调节效应[J].作物学报,2015,41(3):507-513[46] 尹吴,李丽莎,王立科,等.转玉米PEPC基因杨树的光合生理特性分析[J].林业科学,2012,48(6):63-71[47] Chen M,Tang Y,Zhang J,et al.RNA interference-based suppression of phosphoenolpyruvate carboxylase results in susceptibilityof rapeseed to osmotic stress[J].Journal of integrative plant biology,2010,52(6):585-592[48] Rademacher T,Häusler R E,Hirsch H J,et al.An engineered phosphoenolpyruvate carboxylase redirects carbon and nitrogenflow in transgenic potato plants[J].The plant journal:for cell and molecular biology,2002(1):25-39[49] Vidal J,Chollet R.Regulatory phosphorylation of C4 PEP carboxylase[J].Trends in Plant Science,1997,2(6):230-237[50] Kai Y,Matsumura H,Inoue T,et al.Three-dimensional structure of phosphoenolpyruvate carboxylase:a proposed mechanismfor allosteric inhibition[J].Proceedings of the National Academy of Sciences of the United States of America,1999,96(3):823-828[51] Matsumura H,Xie Y,Shirakata S,et al.Crystal structures of C4 form maize and quaternary complex of E.coli phosphoenolpyruvatecarboxylases[J].Structure,2002,10(12):1721-1730[52] Tovar-Méndez A,Mújica-Jiménez C,Muñoz-Clares R A.Physiological implications of the kinetics of maize leafphosphoenolpyruvate carboxylase[J].Plant Physiology,2000(1):149-160[53] Izui K,Taguchi M,Morikawa M,et al.Regulation of Escherichia coli phosphoenolpyruvate carboxylase by multiple effectors invivo. II. Kinetic studies with a reaction system containing physiological concentrations of ligands[J].Journal of biochemistry,1981(5):1321-1331[54] Tovar-Méndez A,Muñoz-Clares R A.Kinetics of phosphoenolpyruvate carboxylase from Zeamays leaves at high concentration ofsubstrates[J].Biochimica et Biophysica Acta,2001,1546(1):242-252[55] Tovar-Méndez A,Rodríguez-Sotres R,López-Valentín D M,et al.Re-examination of the roles of PEP and Mg2+ in the reactioncatalysed by the phosphorylated and non-phosphorylated forms of phosphoenolpyruvate carboxylase from leaves of Zeamays.Effects of the activators glucose 6-phosphate and glycine[J].Biochemical Journal,1998(3):633-642[56] Frank J,Clarke R J,Vater J,et al.Influence of allosteric effectors on the kinetics and equilibrium binding of phosphoenolpyruvate(PEP)to phosphoenolpyruvate carboxylase(PEPC)from Zea mays[J].Biophysical Chemistry,2001,92(1-2):53-64 [57] Echevarria C,Vidal J.The unique phosphoenolpyruvate carboxylase kinase[J].Plant Physiology and Biochemistry,2003,41(6):541-547[58] Echevarria C,Pacquit V,Bakrim N,et al.The effect of pH on the covalent and metabolic control of C4 phosphoenolpyruvatecarboxylase from Sorghum leaf[J].Archives of Biochemistry and Biophysics,1994,315(2):425-430[59] Takahashi-Terada A,Kotera M,Ohshima K,et al.Maize phosphoenolpyruvate carboxylase.Mutations at the putative bindings ite for glucose 6-phosphate caused desensitization and abolished responsiveness to regulatory phosphorylation[J].The journal of biological chemistry,2005,280(12):11798-11806[60] Wang X,Gowik U,Tang H,et al.Comparative genomic analysis of C4 photosynthetic pathway evolution in grasses[J].GenomeBiology,2009,10(6):447-477[61] Shenton M,Fontaine V,Hartwell J,et al.Distinct patterns of control and expression amongst members of the PEP carboxylasekinase gene family in C4 plants[J].Plant Journal,2006,48(1):45-53[62] Uhrig R G,She Y M,Leach C A,et al.Regulatory monoubiquitination of phosphoenolpyruvate carboxylase in germinating castoroil seeds[J].Journal of Biological Chemistry,2008,283(44):29650-29657[63] Shane M W,Fedosejevs E T,Plaxton W C.Reciprocal control of anaplerotic phosphoenolpyruvate carboxylase by invivo monoubiquitination and phosphorylation in developing proteoid roots of phosphate-deficient harsh hakea[J].Plant Physiology,2013(4):1634-1644[64] Ruiz-Ballesta I,Feria A B,Ni H,et al.In vivomonoubiquitination of anaplerotic phosphoenolpyruvate carboxylase occurs atLys624 in germinating sorghum seeds[J].Journal of Experimental Botany,2014,65(2):443-451[65] Ruiz-Ballesta I,Baena G,Gandullo J,et al.New insights into the post-translational modification of multiple phosphoenolpyruvatecarboxylase isoenzymes by phosphorylation and monoubiquitination during sorghum seed development and germination[J].Journal of experimental botany,2016,67(11):3523-3536[66] Figueroa C M,Feil R,Ishihara H,et al.Trehalose 6-phosphate coordinates organic and amino acid metabolism with carbonavailability[J].The plant journal:for cell and molecular biology,2016(3):410-423[67] Denecke M,Schulz M,Fischer C,et al.Partial purification and characterization of stomatal phosphoenolpyruvate carboxylase fromVicia faba[J].Physiologia Plantarum,1993(1):96-102[68] Law R D,Plaxton W C.Purification and characterization of a novel phosphoenolpyruvate carboxylase from bananafruit[J].Biochemical Journal,1995(3):807-816[69] Nisi P D,Zocchi G.Phosphoenolpyruvate carboxylase in cucumber(Cucumis sativus L.)roots under iron deficiency:activity andkinetic characterization[J].Journal of Experimental Botany,2000,51(352):1903-1909[70] Rao S,Reiskind J,Bowes G.Light regulation of the photosynthetic phosphoenolpyruvate carboxylase(PEPC)in Hydrillaverticillata[J].Plant and Cell Physiology,2006,47(9):1206-1216[71] González M C,Osuna L,Echevarría C,et al.Expression and localization of phosphoenolpyruvate carboxylase in developing andgerminating wheat grains[J].Plant Physiology,1998(4):1249-1258[72] Osuna L,Pierre J N,Gonzalez M C,et al.Evidence for a slow-turnover form of the Ca2+-independent phosphoenolpyruvatecarboxylase kinase in the aleurone-endosperm tissue of germinating barley seeds[J].Plant Physiology,1999(2):511-520 [73] Nhiri M,Bakrim N,Bakrim N,et al.Posttranslational regulation of phosphoenolpyruvate carboxylase during germination ofSorghum seeds:influence of NaCl and l-malate[J].Plant Science,2000,151(1):29-37[74] Feria A B,Alvarez R,Cochereau L,et al.Regulation of phosphoenolpyruvate carboxylase phosphorylation by metabolites andabscisic acid during the development and germination of barley seeds[J].Plant Physiology,2008(2):761-774[75] 王丽媛,张玉,徐明怡,等.植物磷酸烯醇式丙酮酸羧化酶的研究进展[J].国土与自然资源研究,2017(5):86-89。

2. 实验试剂:50mM ATP溶液,50mM磷酸肌酸溶液,0.2mM NaHCO3溶液,160U/ml 磷酸肌酸激酶溶液,160U/ml磷酸甘油酸激酶溶液,160U/ml磷酸甘油醛脱氢酶溶液(U为酶活力单位),25mM RuBP溶液,5mM NADH,Rubisco提取介质(40mM Tris-HCl缓冲液,pH7.6,内含10mM MgCl2溶液,0.25mM EDTA,5mM谷胱甘肽),反应介质(0.1M Tris-HCl缓冲液,pH7.8,内含12mM MgCl2溶液,0.4mM EDTA)。
3实验步骤3.1 酶粗提液的准备取新鲜洗干净的条斑紫菜的丝状体和条斑紫菜的叶状体各1克,加入预冷的提取介质1ml,冰浴研磨10min,将样品在40C,10,000×g离心10min,弃沉淀;上清夜即是酶粗提液,置于00C备用(王维光,1985;张志良等,2003)。
3.3.2 Rubisco酶活力的测定按下表配制反应体系:试剂加入量ml5mM NADH 0.250mM ATP 0.2酶提取液0.150mM磷酸肌酸0.20.2mM NaHCO30.2反应介质1.4160U/ml磷酸肌酸激酶0.1160U/ml磷酸甘油酸激酶0.1160U/ml磷酸甘油醛脱氢酶0.1双蒸水0.3将配制好的反应体系混匀,倒入比色杯内,以蒸馏水为空白,在紫外分光光度计计上测量340nm处反应体系的OD值,作为零点值。
将0.1mlRuBp加入比色杯内,立即计时,每隔20s测一次OD值,共测3min。
以零点到第1min 的OD值下降的绝对值计算酶活力。
由于酶提取液中可能存在3-磷酸甘油酸(PGA),会使酶活力的测定产生误差,因此除上述测定外还需做一个不加RuBp的对照。
对照的反应体系与上述酶的反应体系完全一样,所不同的仅仅是把酶提取液放在最后加,加入后马上测定此反应体系340nm处的OD值,并记录前1min内OD值的变化量。

二氧化碳测定试剂盒(PEPC法)适用范围:本品用于体外定量测定人血清中二氧化碳的含量。
1.1规格规格1: (试剂1:30mL);规格2: (试剂1:60mL);规格3: (试剂1:90mL);规格4:(试剂1:120mL);校准品:(选配)规格1(0.3mL×1;1水平);规格2(0.5mL×1;1水平);规格3(1.0mL×1;1水平);质控品:(选配)规格1(0.5mL×2;2水平);规格2(1.0mL×2;2水平)。
1.2组成试剂盒组成见表1表1 二氧化碳测定试剂盒组成注:校准品及质控品赋值具有批特异性,每批次浓度详见标签。
2.1试剂2.1.1外观试剂盒外观应整洁,文字符号标识清晰;组分齐全,液体无漏液;试剂1为浅黄色透明液体,不得有沉淀和絮状物。
2.1.2装量每瓶不少于标示值。
2.1.3试剂空白吸光度用指定的空白样品测试试剂(盒),在光径1cm下,在A405nm处测定试剂空白吸光度A≥0.8。
2.1.4分析灵敏度测定在29 mmol/L范围内的样品,吸光度变化绝对值大于0.05A。
2.1.5线性范围2.1.5.1在[0.5,50] mmol/L内,相关系数R≥0.990。
2.1.5.2在[0.5,15] mmol/L内,线性绝对偏差不超过±1.5mmol/L;(15,50] mmol/L内,线性相对偏差不超过±10%。
2.1.6 重复性重复测试(18±3.6)mmol/L和(34±6.8)mmol/L样本,所得结果的变异系数(CV%)应不大于5%。
2.1.7批间差测定(18±3.6)mmol/L和(34±6.8)mmol/L样本,所得结果的批间相对极差(R)应不大于10%。
2.1.8准确度)中加入一定体积高于50 mmol/L的碳酸氢钠纯在正常浓度范围的临床样本(C品(Cs)或由纯品配制的标准溶液,回收率应在90%-110%范围内。
糖酵解类检测葡萄糖或糖原在无氧或缺氧条件下,分解为乳酸同时产生少量ATP的过程,由于此过程与酵母菌使糖生醇发酵的过程基本相似,故称为糖酵解。
催化糖酵解反应的一系列酶存在细胞质中,因此糖酵解全部反应过程均在细胞质中进行。
糖酵解是所有生物体进行葡萄糖分解代谢所必须经过的共同阶段。
糖酵解迪信泰检测平台使用酶法测定糖酵解过程中的中间产物如果糖-1, 6-二磷酸,对于在糖酵解过程中的酶类物质,采用相应的试剂盒采用生化法检测。
可检测的物质包括己糖激酶、磷酸果糖激酶、果糖-1, 6-二磷酸、丙酮酸激酶等。
此外,我们还提供糖酵解类物质的生化试剂盒代测服务,以满足您的不同需求。
两种酶法测定糖酵解类物质结果比较迪信泰检测平台可检测糖酵解类物质项目果糖-1,6-二磷酸(FDP)己糖激酶(HK)丙酮酸激酶(PK)磷酸果糖激酶(PFK)磷酸烯醇式丙酮酸羧化酶(PEPC)果糖-1,6-二磷酸(FDP)含量检测测定意义:果糖-1,6-二磷酸,又称1,6-二磷酸果糖,是糖酵解途径的重要中间产物之一,在临床上,主要用作治疗心脏缺血症的辅助药物。
测定原理:果糖1,6-二磷酸在醛缩酶催化下发生降解,产物与DNPH反应生成紫红色化合物,在540nm处有最大吸收峰,可利用分光光度法检测果糖-1,6-二磷酸含量。
己糖激酶(HK)活性检测测定意义:己糖激酶是催化己糖磷酸化的酶,参与植物信号转导过程,可调控糖降解和氧化磷酸化途径的代谢速率。
测定原理:己糖激酶催化葡萄糖合成6-磷酸葡萄糖,6-磷酸葡萄糖脱氢酶催化6-磷酸葡萄糖脱氢生成NADPH,NADPH在340nm处有最大吸收峰,可利用分光光度法检测己糖激酶活性。
丙酮酸激酶(PK)活性检测测定意义:丙酮酸激酶,又称磷酸丙酮酸激酶、丙酮酸磷转称酶,是一种转移酶,主要参与糖酵解途径和遗传物质代谢的调控,是糖酵解途径的3个关键酶之一。
测定原理:丙酮酸激酶催化磷酸烯醇式丙酮酸和ADP生成丙酮酸和ATP,乳酸脱氢酶催化NADH和丙酮酸生成乳酸和NAD+,可通过计算340nm处NADH的减少量检测丙酮酸激酶活性。

磷酸烯醇式丙酮酸磷酸酶1 磷酸烯醇式丙酮酸磷酸酶介绍磷酸烯醇式丙酮酸磷酸酶(Phosphoenolpyruvate carboxykinase,PEPCK)是一种广泛存在于细胞和组织中的酶,可以将磷酸烯醇式丙酮酸(PEP)与三磷酸腺苷(ATP)或二磷酸腺苷(ADP)反应生成磷酸丙酮酸(2-PGA)和二磷酸或三磷酸腺苷。
PEPCK在糖异生、脂肪代谢和酸碱平衡等生物过程中起着重要作用。
2 物种和结构PEPCK非常普遍,存在于植物、真菌、细菌和动物中。
目前已经发现了许多物种的PEPCK,其中包括大肠杆菌、酵母菌、果蝇、小鼠和人类等。
这些物种的PEPCK的结构和功能略有不同,但基本上都具有相似的酶学特性。
PEPCK是一种多聚体酶,由4个亚基组成。
每个亚单位具有一个或两个核心结构域,其中一个是PEPCK的保守结构域,称为PEPCK-C区,另一个是变异结构域,称为PEPCK-M区。
PEPCK的C区结构域是关键的催化功能区,包含了活性位点。
3 酶学特性PEPCK在生物过程中起着重要作用。
在糖异生过程中,PEPCK将异丙酰辅酶A(Acetyl-coA)和柠檬酸转化为PEP和CO2,并在某些组织中促进葡萄糖分解产生糖原,同时可通过酯化反应促进脂肪酸合成。
PEPCK还参与调节酸碱平衡,调节胰岛素和葡萄糖等耐量激素的水平,以及参与代谢性疾病的发生发展等生理过程。
除了其功能之外,PEPCK还具有一些独特的酶学特性。
PEPCK是一种高度调节的酶,可通过多种方式调节其活性,包括基因表达、翻译后修饰、核酸修饰和底物浓度等。
其中,最广泛研究的是PEPCK基因的表达和受体调节机制。
4 基因表达和调节在基因表达和调节方面,PEPCK的表达主要受到许多激素和环境因素的调节。
例如,皮质醇、葡萄糖和胰岛素等激素都可以调节PEPCK的表达,而且表达峰值时间和水平也不同。
PEPCK的基因表达受到转录因子的调节。
多个转录因子参与调控PEPCK的表达,包括核因子Y(NF-Y)、脂肪酸转录因子(SREBP)和前列腺素受体(PR)等。

a 磷酸烯醇丙酮酸羧化酶
磷酸烯醇丙酮酸羧化酶(Phosphoenolpyruvate Carboxylase,简称PEPC)是一种参与生物体内能量代谢的酶。
PEPC 主要存在于植物和微生物中,在动物体内也有少量存在。
它在光合作用和糖异生过程中起着关键作用,是将磷酸烯醇丙酮酸(PEP)转化为草酰乙酸(Oxaloacetate)的酶。
PEPC 催化的反应是一个不可逆的羧化反应,需要消耗一分子的水和一分子的二氧化碳。
这个反应是植物和微生物进行光合作用的重要步骤之一,它将二氧化碳固定并转化为有机物质。
在动物体内,PEPC 主要参与糖异生过程,将丙酮酸转化为草酰乙酸,进而合成葡萄糖。
此外,PEPC 还参与了一些其他的代谢途径,如脂肪酸合成和氨基酸代谢。
PEPC 的活性受到多种因素的调节,包括酸碱度、钙离子浓度、代谢产物等。
研究表明,PEPC 在植物体内的表达和活性与植物的光合作用和逆境适应能力密切相关。
总的来说,PEPC 是一种重要的酶,它在生物体内的能量代谢和物质合成过程中起着关键作用。
对于深入了解生物体内的代谢途径和光合作
用机制具有重要意义。
磷酸烯醇式丙酮酸羧化酶(PEPC)提取液简介:磷酸烯醇式丙酮酸羧化酶(Phosphoenolpyruvate carboxylase,PEPC)是C4植物和CAM 植物固定CO 2的关键酶,为催化磷酸烯醇式丙酮酸与二氧化碳反应生成草酰乙酸呈不可逆反应的酶,在植物和细菌中广泛存在,在动物及丝状霉菌中缺乏此酶。
大肠杆菌中的酶分子量约36万的四聚体,可受很多因素的影响,例如可为乙酰辅酶A 活化,可受天门冬氨酸抑制。
此酶是变构酶,主要功能为供给三羧酸循环以草酰乙酸,另外也与C4植物光合二氧化碳固定反应(C4二羧酸循环)及景天科植物的苹果酸形成(景天酸代谢)等有关。
Leagene 磷酸烯醇式丙酮酸羧化酶(PEPC)提取液主要用于裂解植物组织,提取样品中的磷酸烯醇式丙酮酸羧化酶。
该试剂仅用于科研领域,不宜用于临床诊断或其他用途。
组成:自备材料:1、蒸馏水2、离心管或试管3、匀浆器或研钵4、低温离心机操作步骤(仅供参考):1、取植物组织清洗干净,切碎。
2、加入预冷的磷酸烯醇式丙酮酸羧化酶提取液,冰浴情况下充分匀浆或研磨。
3、经纱布或滤纸过滤,留取滤液待用。
3、离心,留取上清液。
4、冻存,用于磷酸烯醇式丙酮酸羧化酶的检测或其他用途。
计算:组织或植物粗酶液获得率(ml)=上清液体积(ml)/组织或植物质量×100%注意事项:编号名称CS0421Storage 磷酸烯醇式丙酮酸羧化酶提取液500ml 4℃使用说明书1份1、待测样品中不能含有磷酸酶抑制剂,同时需避免反复冻融。
2、所测样本的值高于标准曲线的上限,应用磷酸烯醇式丙酮酸羧化酶提取液稀释样品后重新测定。
3、为了您的安全和健康,请穿实验服并戴一次性手套操作。
有效期:6个月有效。
相关:编号名称CC0007磷酸缓冲盐溶液(10×PBS,无钙镁)CS0001ACK红细胞裂解液(ACK Lysis Buffer)DC0032Masson三色染色液DF0135多聚甲醛溶液(4%PFA)NR0001DEPC处理水(0.1%)PS0013RIPA裂解液(强)TC1167尿素(Urea)检测试剂盒(脲酶波氏比色法)。
丙酮酸激酶测定试剂盒使用说明分光光度法货号:BC0540规格:50管/48样产品内容:提取液:60mL×1瓶,4℃保存;试剂一:液体45mL×1瓶,4℃保存;试剂二:粉剂×1支,-20℃保存;试剂三:粉剂×1支,-20℃保存;临用前每支加入 1.5mL双蒸水充分溶解备用,用不完的试剂仍4℃保存一周;试剂四:液体×1支,4℃保存;临用前每支加入900µL双蒸水充分溶解备用,用不完的试剂仍4℃保存一周。
产品说明:PK(EC2.7.1.40)广泛存在于动物、植物、微生物和培养细胞中,催化糖酵解过程中的最后一步反应,是糖酵解过程中的主要限速酶之一,也是产生ATP的关键酶之一,因此测定PK 活性具有重要意义。
PK催化磷酸烯醇式丙酮酸和ADP生成ATP和丙酮酸,乳酸脱氢酶进一步催化NADH和丙酮酸生成乳酸和NAD+,在340nm下测定NADH下降速率,即可反映PK活性。
需自备的仪器和用品:紫外分光光度计、台式离心机、水浴锅、可调式移液器、1mL石英比色皿、研钵、冰和蒸馏水。
操作步骤:一、样本的前处理1、细菌或培养细胞:先收集细菌或细胞到离心管内,离心后弃上清;按照细菌或细胞数量(104个):提取液体积(mL)为500-1000:1的比例(建议500万细菌或细胞加入1mL提取液),超声波破碎细菌或细胞(冰浴,功率20%或者200W,超声3s,间隔10s,重复30次);8000g4℃离心10min,取上清,置冰上待测。
2、组织:按照组织质量(g):提取液体积(mL)为1:5-10的比例(建议称取约0.1g组织,加入1mL提取液),进行冰浴匀浆;8000g4℃离心10min,取上清,置冰上待测。
3、血清(浆)样品:直接检测。
二、测定步骤及加样表:1.分光光度计预热30min以上,调节波长至340nm,蒸馏水调零。
2.工作液的配置:临用前将试剂二转移至试剂一中,充分溶解待用;现配现用。
文献综述磷酸烯醇式丙酮酸羧化酶综述[摘要]磷酸烯醇式丙酮酸羧化酶( PEPC)广泛存在于高等植物、藻类及大多数细菌中, 催化C4光合作用固定CO2的第一步反应。
在过去的10年中关于 PEPC分子的一级结构研究已取得显著的进展, 最近, 通过X- 射线衍射分析阐明了大肠杆菌和米C4型PEPC分子的三维结构, 就这些研究进展进行总结。
关键词: 磷酸烯醇式丙酮酸羧化酶大肠杆菌 PEPC 玉米 C4型 PEPC 分子结构一、磷酸烯醇式丙酮酸羧化酶的分子结构[1]PEPC (EC4.1.1.31)以 Mg2+或 Mn2+为辅助因子,催化磷酸烯醇式丙酮酸(PEP)和HCO3-生成草酰乙酸( OAA)和无机磷酸的不可逆性反应。
PEPC广泛存在于光合生物, 如植物、藻类、蓝细菌和光合细菌中, 还存在于很多非光合细菌和原生动物中。
PEPC催化的反应为细胞各种组分的生物合成提供四碳二羧酸, 参与维持柠檬酸循环, 在初级代谢中有重要的补给作用, 在C4植物和CAM 植物的光合作用中催化大气中CO2固定的第一步反应, 是C4光合作用途径中最重要的酶之一。
所有已知的PEPC均是四聚体,四个相同亚基的分子量大约为95~110k Da。
大多数 PEPC是变构酶, 其活性调控方式为变构作用。
不同种类生物的PEPC有多种变构效应物。
把C4光合作用特异性的PEPC基因导入C3植物中,以期提高C3光合作用效率, 是目前植物基因工程的一个研究热点。
研究结果发现在转基因植物中PEPC的活性也如同在C4植物中一样, 受代谢产物如苹果酸, 6-磷酸葡萄糖(Gluc6-P)和可逆性磷酸化的共价修饰调控。
由于PEPC的变构调控方式和机理很复杂,使PEPC的转基因操作得不到预期的结果, 为此PEPC的分子特性需要通过基因工程改造使之更适合转基因操作的要求。
对PEPC分子结构的研究可以为基因工程改造PEPC的分子特性提供理论依据、为提高C3光合作用固定CO2的效率和作物的产量提供有益的启示。
丙酮酸羧化酶(PC)试剂盒使用说明货号:BC0730规格:50管/48样产品内容:提取液:100mL×1瓶,4℃保存;试剂一:液体47mL×1瓶,4℃保存;试剂二:液体×1支,4℃保存;试剂三:粉剂×1支,-20℃保存;试剂四:粉剂×1支,-20℃保存;产品说明:丙酮酸羧化酶(pyruvate carboxylase,PC,EC6.4.1.1)广泛存在于动物、霉菌和酵母的线粒体中,催化丙酮酸、ATP、CO2和水生成草酰乙酸、ADP和Pi,是糖异生过程的第一个限速酶,在保证血糖的动态平衡方面起着重要的作用。
PC催化丙酮酸、ATP、CO2和水生成草酰乙酸、ADP和Pi,苹果酸脱氢酶进一步催化草酰乙酸和NADH生成苹果酸和NAD+,在340nm下测定NADH氧化速率,即可反映PC活性。
需自备的仪器和用品:分光光度计、台式离心机、可调式移液器、1mL石英比色皿、研钵、冰和蒸馏水。
操作步骤:一、样本的前处理组织、细菌或细胞中胞浆蛋白与线粒体蛋白的分离:1、称取约0.1g组织或收集500万细菌或细胞,加入1mL提取液,用冰浴匀浆器或研钵匀浆。
2、将匀浆600g,4℃离心5min。
3、弃沉淀,将上清液移至另一离心管中,11000g,4℃离心10min。
4、上清液即胞浆提取物,可用于测定从线粒体泄漏的PC(此步可选做)。
5、在步骤④的沉淀中加入1mL提取液,超声波破碎(冰浴,功率20%或200W,超声3秒,间隔10秒,重复30次),用于线粒体PC活性测定。
二、测定步骤1、分光光度计预热30min以上,调节波长至340nm,蒸馏水调零。
2、工作液的配制:临用前将试剂二和试剂三转移到试剂一中混合溶解待用;置于37℃(哺乳动物)或25℃(其它物种)预热5分钟;用不完的试剂4℃保存一周;试剂四的配制:在试剂四瓶中加入2.5mL蒸馏水充分溶解待用;用不完的试剂4℃保存一周;3、在1mL石英比色皿中加入50μL样本、50μL试剂四和900μL工作液,立即混匀,记录340nm处初始吸光值A1和2min后的吸光值A2,计算A=A1-A2。
二氧化碳(CO2)测定试剂盒(PEPC酶法)适用范围:本试剂盒用于体外定量测定人血清中二氧化碳(CO)的浓度。
21.1包装规格1.2主要组成成分试剂主要组分:磷酸烯醇丙酮酸(PEP) 6.3mmol/L磷酸烯醇丙酮酸羧化酶(PEPC) ≥50U/L苹果酸脱氢酶(MDH) ≥100U/L还原型因子≥0.1mmol/L 校准品主要组分:水基质CO2 20-40mmol/L,批特异,具体浓度见瓶签质控品主要组分:水基质CO2 水平1:10-30mmol/L;水平2:20-50mmol/L,批特异,具体浓度见瓶签2.1外观2.1.1试剂应为无色到淡黄色透明溶液,无混浊,无未溶解物。
2.1.2校准品应为无色透明溶液,无混浊,无未溶解物。
2.1.3质控品应为无色透明溶液,无混浊,无未溶解物。
2.2装量液体试剂的净含量应不少于标示值。
2.3试剂空白CO2试剂盒在波长(395~415)nm处测定空白样品的吸光度值,应不小于0.7000。
2.4分析灵敏度试剂盒测试25mmol/L被测物时,吸光度差值(ΔA)应不小于0.0500。
2.5准确度测定国家标准物质GBW06101,相对偏差应不超过15%。
2.6精密度2.6.1重复性重复测试(15.0±3.0)mmol/L、(25.0±5.0)mmol/L和(36.0±6.0)mmol/L 的样本,所得结果的变异系数CV应不大于5%;2.6.2批间差测试(25.0±5.0)mmol/L的样本,所得结果的批间相对极差应不大于10%。
2.7线性范围CO2试剂盒在[3,50]mmol/L范围内,线性相关系数(r)应不小于0.990;在[3,20]mmol/L区间内,线性绝对偏差应不超过±2mmol/L;在(20,50]mmol/L区间内,线性相对偏差应不超过±10%。
2.8质控品赋值有效性重复测定质控品,测定结果应在质控范围内。
磷酸烯醇式丙酮酸羧化酶(PEPC)活性检测试剂盒说明书微量法
注意:正式测定之前选择2-3个预期差异大的样本做预测定。
货号:BC2195
规格:100T/96S
产品内容:
提取液:液体100mL×1瓶,4℃保存;
试剂一:液体15mL×1瓶,4℃保存;
试剂二:液体2mL×1瓶,4℃保存;
试剂三:液体2mL×1瓶,4℃保存;
试剂四:粉剂×1瓶,-20℃保存,临用前加入2mL双蒸水充分溶解待用;可分装后-20℃保存,避免反复冻融;
试剂五:粉剂×1瓶,-20℃保存,临用前加入2mL双蒸水充分溶解待用;可分装后-20℃保存,避免反复冻融;
试剂六原液:液体10μL×1支,4℃保存;
试剂六稀释液:液体5mL×1瓶,4℃保存;
试剂七:粉剂×1瓶,-20℃保存,临用前加入5mL双蒸水,用不完的试剂可分装后-20℃保存,避免反复冻融;
试剂六工作液的配制:将试剂六原液:试剂六稀释液=1μL:329μL稀释,用多少配多少。
产品说明:
磷酸烯醇式丙酮酸羧化酶(EC4.1.1.31)广泛存在于植物和微生物中,是催化磷酸烯醇式丙酮酸与二
氧化碳反应生成草酰乙酸呈不可逆反应的酶,同时也是C4植物和CAM植物固定CO
2
的关键酶,对三羧酸循环的运转起重要调节作用。
PEPC催化磷酸烯醇式丙酮酸和CO
2生成草酰乙酸和HPO
4
2-,苹果酸脱氢酶进一步催化草酰乙酸和NADH
生成苹果酸和NAD+,在340nm测定NADH减少速率,计算PEPC活性。
试验中所需的仪器和试剂:
紫外分光光度计/酶标仪、台式离心机、水浴锅、微量石英比色皿/96孔UV板、可调式移液枪、研钵/匀浆器、冰和蒸馏水。
操作步骤:
一、粗酶液提取:
组织:按照组织质量(g):提取液体积(mL)为1:5~10的比例(建议称取约0.1g组织,加入1mL提取液)进行冰浴匀浆,然后,8000g,4℃,离心20min。
细菌或细胞:按照细菌或细胞数量(104个):提取液体积(mL)为500~1000:1的比例(建议500万细胞加入1mL提取液),冰浴超声波破碎细胞(功率300w,超声3秒,间隔7秒,总时间3min);然后8000g,4℃,离心20min,取上清置于冰上待测。
二、测定步骤:
1、分光光度计/酶标仪预热30min以上,调节波长至340nm,蒸馏水调零。
2、工作液的配制:按体积比试剂二、试剂三、试剂四、试剂五、试剂六工作液、试剂七=15:15:15:15:19:19
的比例混合。
工作液现用现配。
3、操作表:
试剂名称(μL)测定管空白管
试剂一9090
工作液9090
样本20-
蒸馏水-20
在微量石英比色皿/96孔UV板中分别加入上述试剂,充分混匀后于340nm处测定10s时的吸光值A1,迅速置于30℃水浴或培养箱5min(酶标仪有控温功能可将温度调至30℃),拿出迅速擦干测定310s时的吸光值A2,计算△A测定管=A1测定-A2测定,△A空白管=A1空白-A2空白,△A=△A测定管-△A空白管。
空白管只需做一次。
三、PEPC酶活计算:
1、按微量石英比色皿计算:
(1)按蛋白浓度计算
酶活定义:每mg组织蛋白在反应体系中每分钟消耗1nmol NADH定义为一个酶活力单位。
PEPC酶活(U/mg prot)=△A÷(ε×d)×109×V反总÷(V样×Cpr)÷T=321×△A÷Cpr
(2)按样本质量计算
酶活定义:每g组织在反应体系中每分钟消耗1nmol NADH定义为一个酶活力单位。
PEPC酶活(U/g鲜重)=△A÷(ε×d)×109×V反总÷(V样×W÷V样总)÷T=321×△A÷W
(3)按细菌或细胞数量计算
酶活定义:每104个细菌或细胞每分钟消耗1nmol NADH定义为一个酶活力单位。
PEPC酶活(U/104cell)=△A÷(ε×d)×109×V反总÷(V样÷V样总×细胞数量(万个))÷T
=321×△A÷细胞数量(万个)
ε:NADH摩尔消光系数,6.22×103L/mol/cm;d:比色皿光径,1cm;
V反总:反应体系总体积,2×10-4L;V样:反应体系中样本体积,0.02mL Cpr:样本蛋白浓度,mg/mL;W:样本质量,g;
V样总:加入提取液体积,1mL;T:反应时间:5min;
109:单位换算系数,1mol=109nmol。
2、按96孔UV板计算:
将上述公式中的d-1cm改为d-0.6cm(比色皿光径)进行计算即可。
注意事项:
1、为保证实验结果的准确性,需先取1-2个样做预实验,△A大于0.6时,建议将粗酶液用提取液稀释后
再进行测定。
当△A小于0.01时,可以延长反应时间(10min或15min)来测定。
2、空白管为检测各试剂组分质量的检测孔,正常情况下,变化不超过0.01。